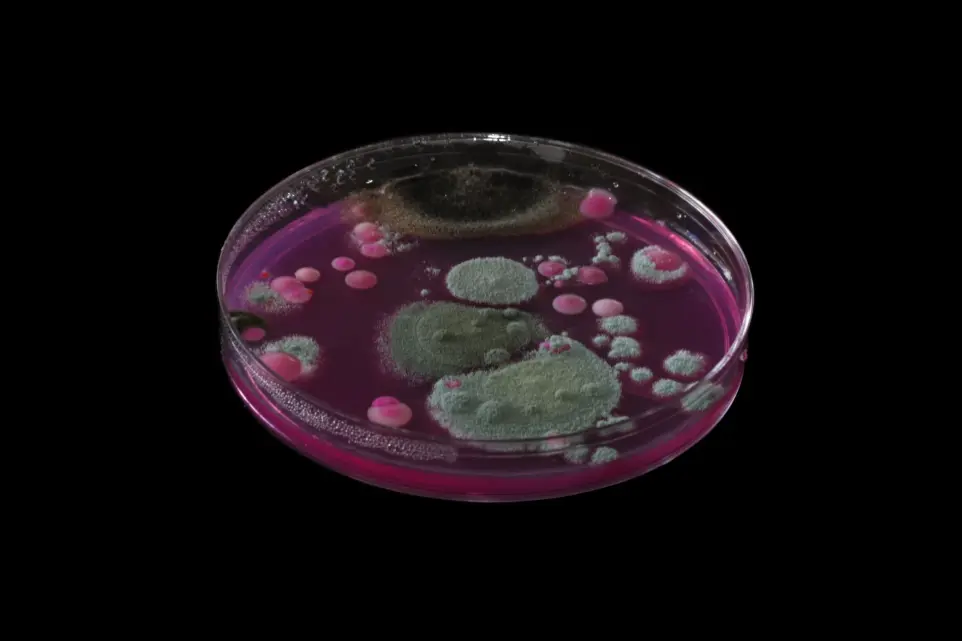
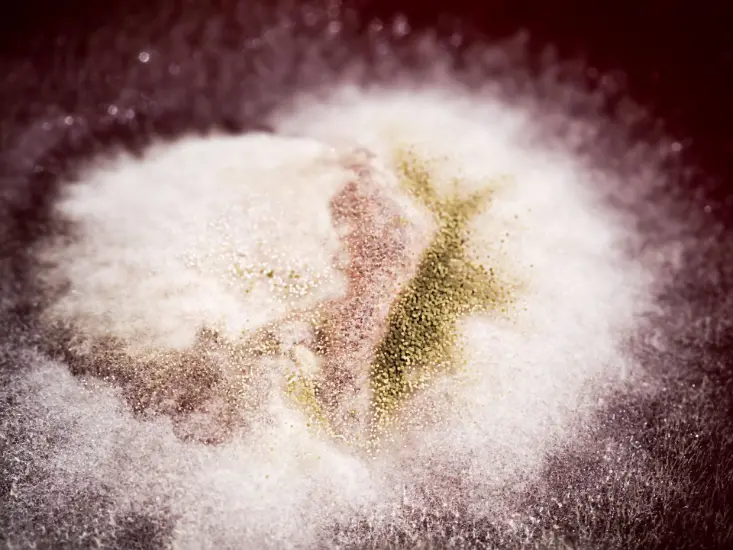

Understanding Fungal Diseases: Causes, Types, and Prevention
Fungal diseases range from mild skin conditions to life-threatening systemic infections. Understanding the causes, symptoms, and prevention strategies is vital for protecting health and avoiding chronic infections.
Regular hygiene, awareness of risk factors, and timely medical treatment remain the best defenses against fungal pathogens.

What Are Fungal Diseases?
Fungal diseases also called mycoses are infections caused by fungi (champignons) that live in soil, plants, water, and even on human skin. While most fungi are harmless, some species can cause disease when they overgrow or enter the body through the skin, lungs, or mucous membranes.
There are millions of fungal species, but only a few hundred are known to make humans sick. Fungal infections can be superficial (affecting the skin, nails, or hair) or systemic (affecting internal organs) .
Common Causes of Fungal Infections
Fungal infections develop when environmental conditions and body defenses allow fungi to multiply. Common causes include:
Weak immune system (HIV, cancer, diabetes)
Use of antibiotics or corticosteroids
Warm and humid environments
Contact with contaminated soil or surfaces
Poor hygiene or excessive sweating

Major Types of Fungal Diseases
1. Superficial and Cutaneous Mycoses
These affect the skin, nails, and hair.
Ringworm (Tinea) caused by Trichophyton or Microsporum species.
Athlete’s Foot (Tinea pedis) itchy, peeling skin between toes.
Nail Fungus (Onychomycosis) thickened or discolored nails.
2. Mucosal Fungal Infections
Oral Thrush caused by Candida albicans, often seen in infants or immunocompromised patients.
Vaginal Yeast Infection itching, discharge, and irritation due to Candida overgrowth.
3. Systemic and Opportunistic Mycoses
These are serious infections that spread through the bloodstream.
Aspergillosis caused by Aspergillus spores inhaled from the air, affecting the lungs.
Cryptococcosis caused by Cryptococcus neoformans, can infect the brain.
Histoplasmosis from inhaling spores in bird or bat droppings.
Diagnosis and Treatment
Fungal infections are diagnosed using:
Microscopic examination
Culture tests
PCR and molecular methods
Histopathology staining (PAS, GMS)
Treatment depends on the infection type and severity:
Topical antifungals (clotrimazole, terbinafine) for skin infections
Oral antifungals (fluconazole, itraconazole) for deeper infections
IV antifungal therapy (amphotericin B, voriconazole) for systemic diseases

Prevention Tips
Keep skin clean and dry
Avoid sharing towels, shoes, or personal items
Wear breathable fabrics
Use antifungal powder in humid climates
Strengthen immunity through balanced diet and sleep

Fungal Diseases in Public Health
Fungal infections are often underestimated but can cause severe illness in vulnerable populations. According to the World Health Organization (WHO), invasive fungal diseases are a growing global threat, especially among patients with cancer, HIV/AIDS, or post-transplant immunosuppression.
Early diagnosis, public awareness, and access to antifungal medications are essential to reduce global morbidity and mortality caused by fungal pathogens.